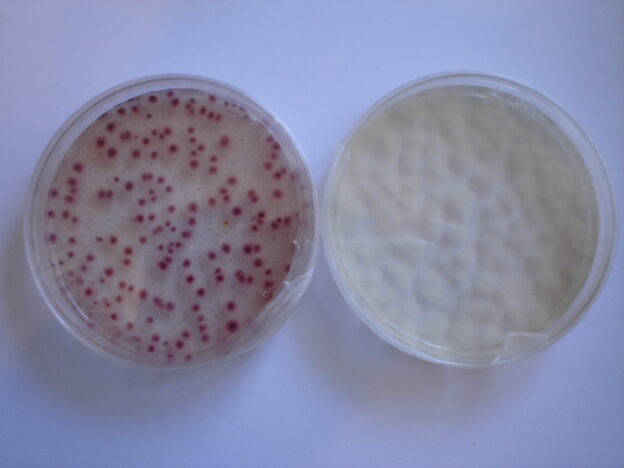

RECUENTO DE AEROBIOS EN COSMÉTICOS, MÁS FIABLE Y MÁS RÁPIDO, SIN INVERSIÓN EN EQUIPOS PARA TÉCNICAS ESPECIALES
RECUENTO DE AEROBIOS EN COSMÉTICOS, MÁS FIABLE Y MÁS RÁPIDO, SIN INVERSIÓN EN EQUIPOS PARA TÉCNICAS ESPECIALES
Del mismo modo que el PCA cromogénico de MICROKIT permite un recuento más cómodo, fiable y rápido en alimentos. Y que el YEA cromogénico lo hace en aguas. Maxim Rapid Cromogenic Agar (base TSA) permite contar en cosmética colonias rojas sobre fondo crema, distinguiéndolas de partículas de muestra y en sólo 18-36 horas.
https://www.microkit.es/fichas/CROMOKIT-MAXIM-AGAR-CROMOGENICO.pdf
Las validaciones realizadas sobre este medio, tanto por MICROKIT como por los laboratorios que lo emplean, demuestran estas tres afirmaciones:
1-Aumenta la fiabilidad, ya que las colonias crecen rojas y contrastan con el color crema del medio, a diferencia del TSA o del Eugon Agar, Letheen Agar, etc. Esto además ayuda a forzar/desgastar mucho menos la vista de los analistas al realizar los recuentos. Las partículas de muestra y burbujas no son interpretadas como colonias falsamente positivas. Y las colonias diminutas no pasan desapercibidas como falsos negativos.
2-Permite mayor comodidad al analista, por lo ya explicado sobre el contraste de las colonias rojas sobre el medio crema (ver fotografía comparativa)
3-Aumenta la rapidez de resultados, ya que precisamente ese mismo contraste colonias/medio, permite verlas mucho antes, incluso desde las primeras 18 horas si se incuba a 35ºC (aerobios asociados al hombre) y desde las primeras 36 h si se incuba a 22ºC (aerobios saprófitos, alterativos a las temperaturas de almacenamiento).
Maxim Rapid Cromogenic Agar tambien está disponible en las cómodas placas deshidratadas: siembra en masa de 1 mL sin tener que calentar ni enfriar agares, ¡de la muestra a la estufa en 10 segundos!
https://www.microkit.es/fichas/Dry-Plates-TSA-crom-y-SDA-Caf-Prospecto.pdf
El medio cromogénico es un invento de Microkit de 1995. Y como pioneros en el tema, ofrecemos la gama más completa del mercado de estos medios enzimáticos/específicos, incluido este para recuento de aerobios, además de los más conocidos para patógenos, los caldos cromogénicos para P/A y NMP, etc.
Empleando Maxim Rapid Cromogenic Agar para recuento de aerobios y Rapid Sabouraud YM Agar para recuento de hongos (levaduras y mohos), el laboratorio de cosmética deja de tener los recuentos como freno durante 5 dias a la liberación de los lotes. Y el nuevo freno pasa a ser la detección de patógenos tras enriquecimiento (3-4 días). Lo que ahorra 2 dias de stock de producto final en cuarentena. A un coste similar al de la liberación en 5 días.
https://www.microkit.es/fichas/rapid-ym-agar.pdf
También disponible en DryPlates-RYM
¿Qué pensará el empresario si sabe que puede ahorrarse la millonada de 2 dias de stock, sin inversión en técnicas caras, pero su laboratorio todavía no lo está aprovechando?
Haga sus consultas de MAXIM Rapid Cromogenic Agar en: microkit@microkit.es
Haga sus pedidos de MAXIM Rapid Cromogenic Agar en pedidos@microkit.es
No se pierda nuestro video: https://youtu.be/qE2gNZH9KWQ?si=sAKHe8KqtGkBua9V